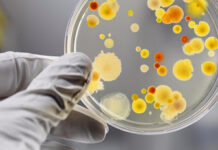
Гострі кишкові інфекції: на Вінниччині фіксують нестабільну епідситуацію

У “Пироговці” успішно провели надскладну операцію на печінці
У Вінницькій обласній клінічній лікарні імені М. І. Пирогова зафіксували випадок, коли один з пацієнтів звернувся із скаргами на біль у верхній частині живота,...
П’ять порад для швидкого засинання та глибокого сну
Здоровий сон забезпечує організм енергією на весь день. Багато проблем зі сном можна уникнути, дотримуючись правильного розпорядку дня.Фахівці підготували п’ять порад, які допоможуть швидше...
Директоркою Клінічного Центру інфекційних хвороб призначено Валентину Зайцеву
Відповідне розпорядження підписав голова обласної Ради Вячеслав Соколовий, повідомили на сайті Вінницької обласної ради.Із 17 листопада 2023 року до сьогодні медичний заклад очолював Ігор...
На Вінниччині зростає кількість хворих на гострі кишкові інфекції
В офіційному медіацентрі обласної військової адміністрації відбувся брифінг директора Вінницького обласного центру контролю і профілактики хвороб Ігоря Матковського. Спікер надав оновлену інформацію щодо моніторингу...
Які медичні послуги можна отримати безоплатно без направлення
Міністерство охорони здоров'я України спростувало поширений міф про те, що без направлення жодну медичну допомогу в лікарнях не нададуть безоплатно.Насправді це неправда. Держава гарантує...
На Вінниччині розпочав роботу пересувний мамограф «Квітка»
У червні пересувний мамограф «Квітка» працюватиме у 8 громадах Вінницької області. Як повідомляє департамент охорони здоров’я Вінницької ОВА, лікарі вже провели обстеження жінок у...
Гострі кишкові інфекції: на Вінниччині фіксують нестабільну епідситуацію
В офіційному медіацентрі обласної військової адміністрації відбувся брифінг Ігоря Матковського, керівника Вінницького обласного центру контролю і профілактики захворювань. Він представив результати моніторингу інфекційних захворювань...
Чи безпечний ваш манікюр? УФ-лампи та ризик розвитку раку шкіри
Дослідження показали, що УФ-лампа, яка використовується для сушіння гель-лаку, може пошкоджувати ДНК і збільшувати ризик розвитку раку шкіри. Через це вчені рекомендують уникати такого...
Громади Вінниччини можуть отримати до 400 тис. грн на створення адаптивних спортивних клубів
За даними Міністерства молоді та спорту України, лише 15% населення України регулярно займається фізичною активністю чи спортом. Проте цей показник значно менший, якщо йдеться...
Вінницька обласна дитяча лікарня отримала цінне медичне обладнання від International Medical Corps UK
Вінницька обласна дитяча клінічна лікарня отримала важливу допомогу від представників International Medical Corps UK. Лікарні було подаровано добовий монітор електрокардіосигналів та непрямий офтальмоскоп.Як зазначають...